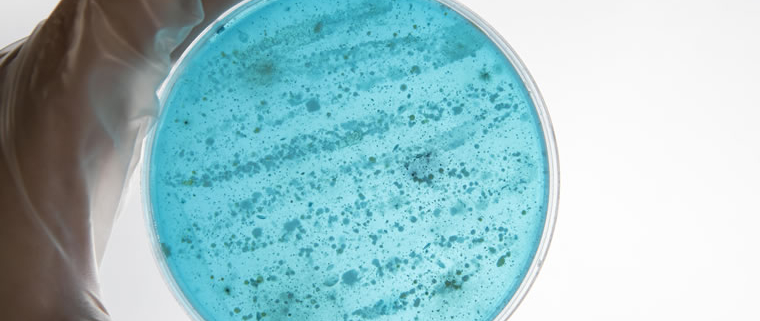

Legionella Testing Methods Compared
Legionella Testing Methods Compared Legionella testing plays a valuable role in understanding and controlling the risk of bacteria within man-made water systems. While not always a legal requirement, testing provides a practical way to verify that control measures are working effectively and that conditions remain unfavourable for bacterial growth. From traditional laboratory-based methods to newe